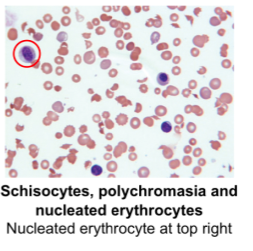
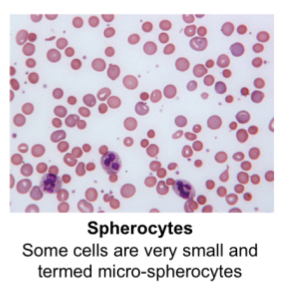
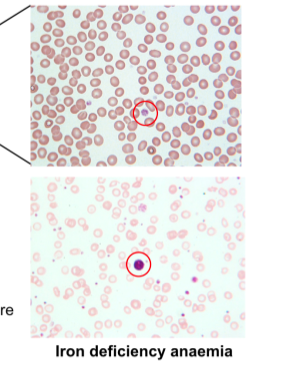

What are the primary causes of anaemia?
What are the signs of anaemia?
What are the symptoms of anaemia?
Rarely: headaches, tinnitus, taste disturbance.
More severe symptoms: Jaundice, splenomegaly, hepatomegaly, angina, cardiac failure, fever.
What form of anaemia would be indicative in dark urine?
Haemolytic anaemia.
What are the aetiological casses of anaemia?

Give an overview of the process of Erythropoiesis
Regulated by stem cell cytokines:

What are conditions that affect specifically erythropoiesis in the bone marrow?
They are termed pure red cell aplasia (PRCA).
Most common PRCA is Diamond-Blackfan anaemia.
What is Pancytopenia?
Pancytopenia is a condition that affects other cell types in addition to RBCs (including white cells and platelets).
What is the common hallmark of Diamond-Blackfan anaemia?
What is the difference between accquired and secondary PRCA?
Primary - idiopathic - where no clear cause can be identified or secondary (accquired as a result to exposure to a pathogenic agent such as a drug or infection).
How can you get anaemia from changes in the bone marrow?

How else can pancytopenia manifest from changes in the bone marrow?

What are the causes of haemolytic anaemia?
What are Alloantibodies?
Alloantibodies are produced in response to the immune recognition of foreign erythrocytes that have been introduced via a blood transfusion or due to pregnancy (following the mixing of maternal and foetal blood at delivery)
What is haemolytic disease of the newborn (HDN)?

What are the causes of Auto-Immune haemolytic anaemia (AIHA)
In blood films, what are shistocytes?
They are fragments parts of a red blood cell. Irregularly shaped and jagged. They result from fragmented destruction of red blood cells.
What are spherocytes?
Some cells are termed very small and termed micro-spherocytes.
What are nucleated erythrocytes?
A red cell with a nucleus that is usually lysed.
What are Haemoglobinopathy’s?
Haemoglobinopathies are autosomal co-dominant genetic defects resulting in abnormal structure of one of the globin chains of the haemoglobin molecules.
Sickle cell anaemia is one of the most common haemoglobinopathies.
What are the causes of sickle-cell anaemia?
Sickle cell anaemia is attributed to mutations in the beta-globin gene.
Sickle cell erythrocytes are an abnormal shape, which affects their passage through the circularatory system, their ability to carry O2 and increased haemolysis.
Sickle cell anaemia can cause vaso-occlusive crises (vessel blockage), visceral sequestration crisis, aplastic and haemolytic crises.
Describe the structure of haemoglobin
Each erythrocyte contains 640 million haemoglobin molecules.

What vitamins and minerals are needed for erythropoiesis?
Vitamin B12, B6 and Folic Acid.
What causes iron-deficiency anaemia?
The essential micronutrients, irons, vitamins, b12 and b6 and folic acid, are required for various steps in regulating erythrocyte function, especially for the metabolism of haem.
Each molecule of haemoglobin must have an atom of iron to which O2 can bind to in the lungs. Therefore a lack of iron directly impacts the amount of O2 that can be transported to the tissues.